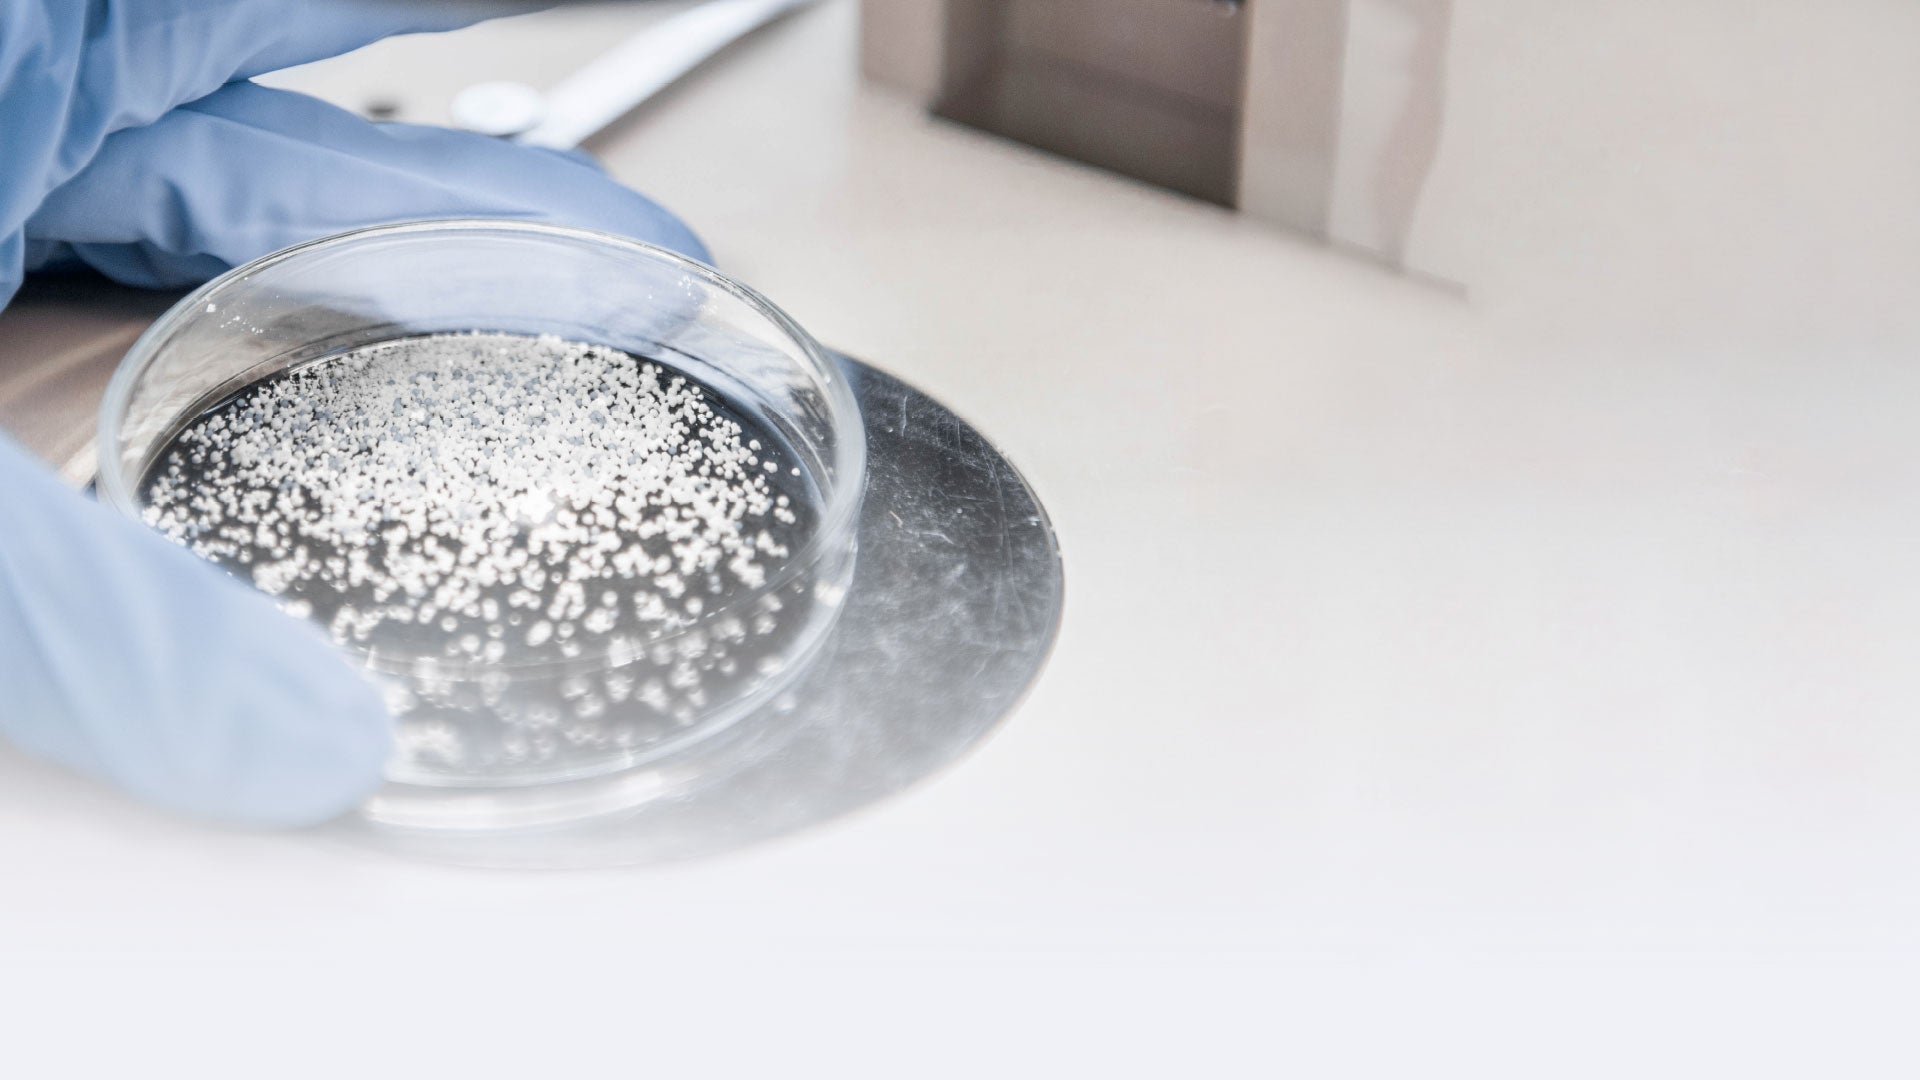

Welcome to our webshop
High-purity calcium phosphates products for research and innovation.
Featured products
Explore CAM Bioceramics' full range calcium phosphates (CaPs) products ideal for medical device manufactures and research institutions, seeking for high- quality CaPs, in-house produced Hydroxyapatite (HA), β- and α- tricalcium phosphates (β,a-TCP), and more.

Register now
This webshop is exclusively for academic institutions, universities, and research professionals who need premium-grade calcium phosphate products for developing medical devices. Available in 20g, 100g, and 250g units. *Account approval required for purchase access.
Made for research. Trusted by industry.
CAM Bioceramics supplies products manufactured under ISO 13485 certified quality management system that meets the strict requirement of medical device manufactures. Order your sample in the webshop, or speak with our team quantities higher than 250g and/or to discuss your application requirements.

Suited for Medical Devices and Pharmaceuticals
ISO 13485:2016
Our Quality Control lab operates under ISO 13485:2016 and GMP standards. Measurement methods follow relevant norms, such as ISO 13320 for laser diffraction. Where specified, our materials meet key industry standards including ASTM F1185 and ISO 13779-6 for Hydroxyapatite, and ASTM F1088 and ISO 13175-3 for Beta-TCP.

Made in Holland
In-house manufacturing
Our production facility is built to support both specialized and high-volume manufacturing needs. Whether you're developing a niche medical device or scaling up a global product line, CAM Bioceramics delivers consistent, on-spec calcium phosphate products.

Technical support
Research and Development
We partner with research institutes, universities and medical device manufacturers to co-develop calcium phosphate-based solutions tailored to specific clinical or product requirements. From initial prototyping to full-scale production.






